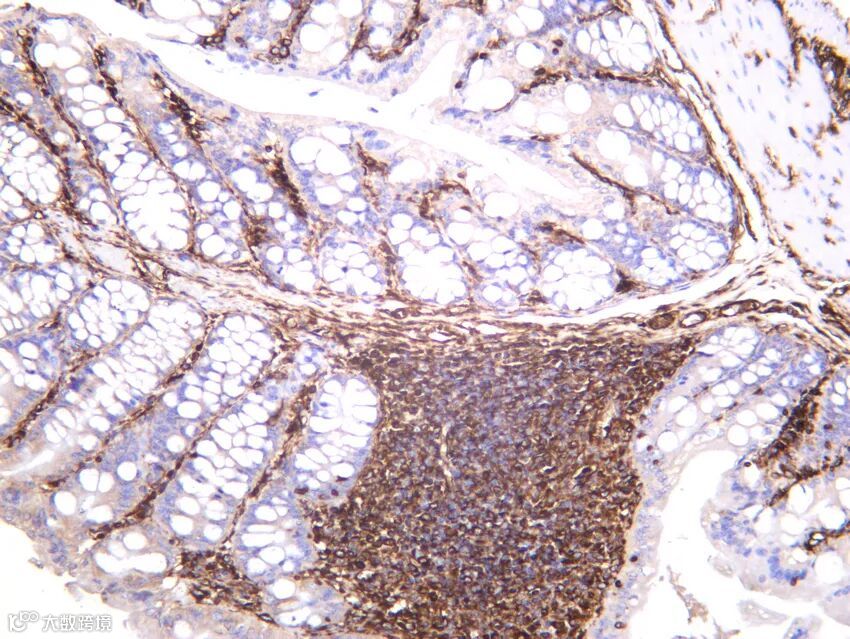
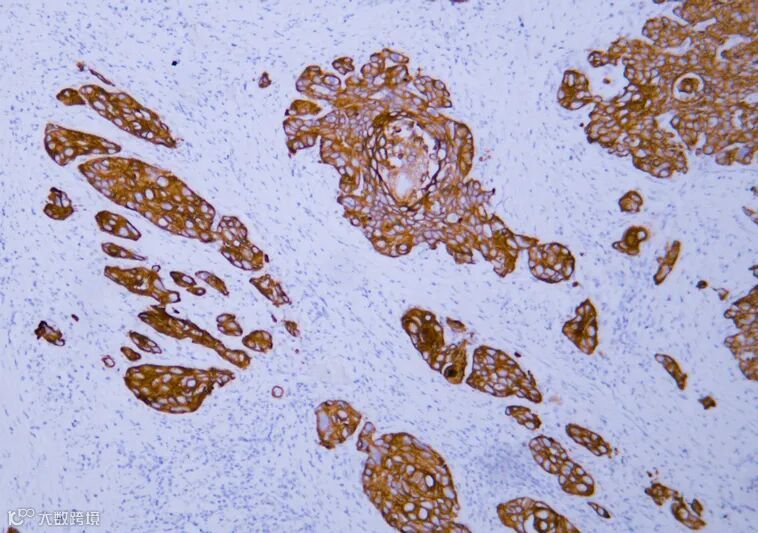
fe93bfc09da146b59c206a3dbaeb0763_V0280-esophageal-squamous-cell-carcinoma.jpg

免疫组化(IHC)利用抗原与抗体特异性结合,通过显色反应判断组织和细胞中靶标抗原的表达情况。其本质是用分子标记物对组织细胞内的靶标抗原进行原位可视化示踪,既是临床诊断中必不可少的辅助技术;也是基础研究的核心支撑。

图中展示了免疫组化的基本类型。(A)直接法,(B)间接法,(C)过氧化物酶-抗过氧化物酶(PAP)法,(D)生物素-亲和素复合物(ABC)法,(E)标记链霉亲和素-生物素(LSAB)法,(F) 聚合物法,(G&H)酪胺信号放大法。

免疫组化结果的科学解读能精准分析病理特征、判断疾病分型(如肿瘤类型)和病灶来源、检测在常规HE染色中不明显的微小病灶、评估预后效果等。尤其多个标记物检测的综合分析,能更精确判断疾病分型,对于治疗方案的调整和预后判断提供极大助力。

上图为混合性神经内分泌-非神经内分泌肿瘤。综合多个靶点染色分析,能更清晰区分肿瘤类型以及各肿瘤区域。(A)源于腺瘤的结肠癌,(B)常规腺癌,(C)低分化神经内分泌癌(NEC),(D)CDX2在结肠黏膜、腺瘤和腺癌中表达,但在 NEC 中几乎缺失,(E)突触素则呈现相反的模式, (F) Rb 缺失仅限于NEC。
免疫组化通常用“+/-”表示信号强弱,“-”表示阴性,即未检测到靶标抗原;“+”表示阳性,即检测到靶标抗原,阳性表达存在强弱及数量的差异;采用不同数量的“+”表达强弱差异,即弱阳性(+)、中阳性(++)、强阳性(+++)。颜色也表达强弱差异,淡黄色代表弱阳性,棕黄色为中阳性,棕黑色为强阳性。

图为Merkel细胞癌的免疫组化检测结果,(A) 肿瘤HE染色,(B)CK20,(C)神经丝蛋白,(D)核内T抗原。

免疫组化结果的精准解读需要结合靶蛋白的亚细胞定位(核蛋白、膜蛋白、分泌蛋白)、组织表达的生物学特性(如特异性标记物)和信号强弱等方面综合分析。
例如,传统的通用神经内分泌标志物包括突触素(synaptophysin)和嗜铬粒蛋白A(chromogranin A),神经内分泌肿瘤(NET)/嗜铬细胞瘤(PHEO)/副神经节瘤(PARA)基本始终表现出弥漫性强嗜铬蛋白A和/或突触素阳性,若染色弱于此则诊断存疑;但是,约1/4的神经内分泌癌(NEC)为嗜铬粒蛋白A/突触素阴性,在NEC中INSM1取代了嗜铬粒蛋白A和突触素成为特异性诊断标记物;Rb失活是小细胞肺癌的分子遗传学标志,是敏感的NEC标记物;≥80%的NEC中可见CXCR4过表达,二者对NEC具有相当的特异性。

肺肿块小细胞神经内分泌癌。(A)肿瘤HE染色,(B)Keratin AE1/AE3呈阳性,(C)突触素和嗜铬粒蛋白A为完全阴性,(D)INSM1呈阳性,(E)Rb表达缺失,(F)CXCR4呈弥漫性强膜染色。


免疫组化在临床和科研中已成为连接组织形态与分子特征的关键桥梁,HE染色能清晰显示“癌细胞”的形态,但更精准的疾病分型、对应的治疗方案确认,以及预后效果需要依赖对标志物的染色来实现。
正如上文介绍的对NET/PHEO/PARA/NEC的鉴定,几乎没有哪个标记物能对任何一种肿瘤类型具有完全的特异性,因此需要借助多靶点标志物进行综合分析。以下展示了部分免疫组化中常用的标志物。
Chromogranin A
(PT0092R) PT™ Rabbit mAb
货号:YM8054


Synaptophysin (PT0840R) PT™ Rabbit mAb
货号:YM8609
GFAP (PT0298R) PT™ Rabbit mAb
货号:YM8172

Vimentin (PT0495R) PT™ Rabbit mAb
货号:YM8324
CD31 (PT0350R) PT™ Rabbit mAb
货号:YM8207

Cytokeratin pan
(ABT154) Mouse mAb
货号:YM6815
p63 (PT0645R) PT™ Rabbit mAb
货号:YM8454


CD20 (PT1453R) PT™ Rabbit mAb
货号:YM9295
CD3 (PT0212R) PT™ Rabbit mAb
货号:YM8134


CD68 (PT0547R) PT™ Rabbit mAb
货号:YM8367
Ki-67 (PT0321R) PT™ Rabbit mAb
货号:YM8189

注:点击货号可进入产品链接。

为了满足多个抗原同时检测的需求,基于免疫组化原理开发的多重荧光免疫组化试剂盒,解锁组织/细胞微环境的高维密码,突破传统染色限制,精准解析细胞互作与分子共定位,可以实现多个靶点在同一张切片共染。
|
|
|
|
鼠兔三标四色荧光检测试剂盒 |
1mL 2mL 5mL |
|
鼠兔双标三色荧光检测试剂盒 |
1mL 2mL 5mL |
|
鼠兔四标五色荧光检测试剂盒 |
1mL 2mL 5mL |
|
鼠兔五标六色荧光检测试剂盒 |
1mL 2mL 5mL |
|
鼠兔六标七色荧光检测试剂盒 |
1mL 2mL 5mL |
|
兔三标四色荧光检测试剂盒 |
1mL 2mL 5mL |
|
兔双标三色荧光检测试剂盒 |
1mL 2mL 5mL |
|
兔四标五色荧光检测试剂盒 |
1mL 2mL 5mL |
|
兔五标六色荧光检测试剂盒 |
1mL 2mL 5mL |
|
兔六标七色荧光检测试剂盒 |
1mL 2mL 5mL |
|
鼠三标四色荧光检测试剂盒 |
1mL 2mL 5mL |
|
鼠双标三色荧光检测试剂盒 |
1mL 2mL 5mL |
|
鼠四标五色荧光检测试剂盒 |
1mL 2mL 5mL |
|
鼠五标六色荧光检测试剂盒 |
1mL 2mL 5mL |
|
鼠六标七色荧光检测试剂盒 |
1mL 2mL 5mL |


1.https://doi.org/10.1177/0192623318776907
2.https://doi.org/10.1016/j.humpath.2019.12.002
3.https://doi.org/10.1111/his.12298
About
关于睿捷生物科技有限公司
睿捷生物科技有限公司是 (realgen-bio Co., Ltd.,简称睿捷生物)致力于为国内生命科学领域提供先进、专业的仪器设备、试剂耗材的企业。公司目前是近20家国内外知名生物公司的一级代理商,为客户提供从研发到生产的各类实验室仪器,检测试剂和生产设备。
公司产品领域涵盖分子生物学、免疫学、血液学、肿瘤研究、信号通路、药物筛选、干细胞研究、神经生物学、表观遗传学等等,为用户提供系统性的科学研究完整解决方案,成为众多研究者们可以信赖的选择。
公司成立于2011年,总部位于苏州,在南京、济南、合肥都设有办事处,公司客户主要为国内领先的生物制药、细胞治疗、生物医学和各类生物技术公司,以及大量的生命科学基础研究和政府实验室,目前已服务客户单位4000余家。

睿捷-企业文化
公司的使命:高效服务客户、为客户持续创造价值
公司的愿景:将人与科技相结合,成为生命科学领域一流的解决方案供应商
公司的价值观:诚信、公开、坚持、分享
睿捷-合作伙伴



